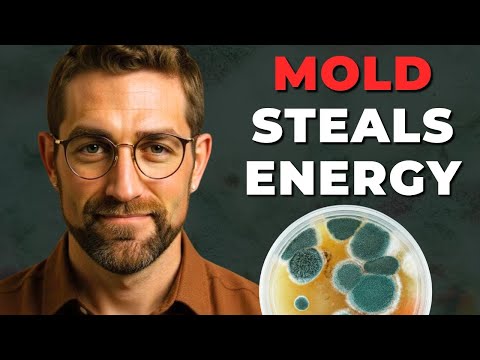
Mold and Mitochondria: The Overlooked Link Behind Low Energy

The Mitochondria Protocol: How to Actually Fix Your Energy
About
No channel description available.
Latest Posts
Video Description
π¬ The scientific truth about why you're tired, explained by Stanford-trained physician Dr. Hillary Lin. Discover: β The real reason for low energy (it's in your cells) β Why most energy fixes fail β The latest science on cellular power β A complete protocol for lasting energy β Prevention strategies that work In this comprehensive guide, learn: - How your cellular batteries actually work - Why modern life drains your energy - The brain-energy connection - Exercise that actually helps - Scientific solutions for fatigue π Special Focus: Understanding the connection between mitochondrial health and energy levels. Learn why traditional approaches often fail and discover the latest scientific protocols for cellular energy optimization. π‘ Who This Is For: - Anyone struggling with fatigue - Health optimizers seeking better energy - Athletes looking for an edge - People interested in longevity - Those with chronic low energy π― You'll Learn: - The science of cellular energy - How to assess your mitochondria - Which interventions work best - Implementation strategies - Progress optimization *Chapters* 00:00 The Power Within: Understanding Mitochondrial Health 03:48 The Cellular Power Plant 06:45 Mitochondrial Inheritance and Human History 09:54 Mitochondria and Brain Function 14:10 Heart Health and Mitochondrial Function 18:14 A Deep Dive into Cellular Power 22:14 Practical Strategies for Mitochondrial Health #mitochondria #cellularhealth #energy #fatigue #longevitymedicine #medicine #wellness #health #biohacking #science β¨ Get 5 Easy Longevity Tips & Dr. Hillary Linβs Weekly Newsletter for Free: https://www.hillarylinmd.com/subscribe *About the Show:* The Longevity Show with Dr. Hillary Lin takes complex medical research and distills it into practical, easy-to-understand advice for living a longer, healthier life. Covering everything from preventative medicine and metabolic health to the latest breakthroughs in nutrition, exercise, and mental wellness, Dr. Lin gives you the tools you need to thrive. *Connect with Dr. Hillary Lin:* Instagram: https://www.instagram.com/hillarylinmd Facebook: https://www.facebook.com/hillarylinmd X: https://twitter.com/hillarylinmd TikTok: https://www.tiktok.com/@hillarylinmd Got questions? Ask Dr. Hillary Lin directly on NoomVibe: https://noomvibe.app/hillarylinmd/ask *Disclaimer:* This podcast is for informational purposes only and does not constitute medical advice, diagnosis, or treatment. No doctor-patient relationship is formed. Always seek the advice of your physician or other qualified healthcare provider with any questions you may have regarding a medical condition. Use of this information is at your own risk.
Upgrade Your Everyday
AI-recommended products based on this video

Kasa Smart Outdoor Smart Plug by TP-Link (KP400) - Smart WiFi Outlet with 2 Sockets, IP64 Waterproof, Works with Alexa and Google Home, 2.4GHz WiFi Required, No Hub Required, Sunset & Sunrise Offset

Wireless Earbuds, Bluetooth 5.4 Headphones in Ear with 4 ENC Noise Cancelling Mic, in Ear Earphones 40H, IP7 Waterproof, USB C, Bluetooth Ear Buds for Sports, Gym, Workout, Rose Pink

Wireless Earbuds, Bluetooth 5.4 Headphones in Ear with 4 ENC Noise Cancelling Mic, in Ear Earphones 40H, IP7 Waterproof, USB C, Bluetooth Ear Buds for Sports, Gym, Workout, Black

Fvyao Sleep Earbuds, Mini Wireless Earbuds in Ear, Sleep Headphones Design for Side Sleeper, 24H Bass Stereo, Bluetooth 5.4, with ENC Noise Cancelling, IPX6 Waterproof Ear Buds for Android iOS

Oraolo Open Ear Headphones, Bluetooth 5.4 Wireless Earbuds with Stereo Sound, ENC Clear Call, 21H Playtime, Type-C Charging, Touch Control, IPX6 Waterproof Open Ear Clip-On Earbuds for outdoor workout

Brita Stainless Steel Premium Filtering Water Bottle, BPA-Free, Reusable, Insulated, Replaces 300 Plastic Water Bottles, Filter Lasts 2 Months or 40 Gallons, Includes 1 Filter, Carbon - 20 oz.

Simple Modern Filtered Water Bottle | Insulated Stainless-Steel Carbon Filter Travel Water Bottles | Reusable for Clean Drinking Water On The Go | 24oz, Sea Glass Sage

FITVII Health & Fitness Tracker (Answer/Make Calls), Smart Watch with 24/7 Heart Rate and Blood Pressure, Sleep Tracking Monitor, 120+ Sport Mode Activity Tracker

AYATAHA AYATAHA Smart Watch for Kids, Smartwatch Fitness Tracker for Boys Girls, Children's Activity Watch 37 Sports Modes SMS Notification, HD Full Touchscreen IP67 Waterproof, Blue

Iaret Iaret Smart Watch for Women, 1.83" HD Fitness Tracker with 4 Bands, Answer/Make Calls, Heart Rate/Sleep/SpO2/Step Tracking, 100+ Sport Modes, Android/iPhone Compatible Gift (Rose Gold)

Smart Watch for Men Women 1.8" Fitness Tracker, Bluetooth Call, DIY Dial, Heart Rate Sleep Blood Oxygen Monitor, 100+ Sports Modes, IP68 Waterproof Smartwatch for Android iPhone, Alexa Built-in

Hand Warmers 2 Pack, 14000mAh Rechargeable Hand Warmers, Electric Hand Warmer Reusable, Portable Power Bank USB Hand Warmers 4 Levels 8 Heating, Gifts for Raynauds Ski Golf Camping

Hand Warmers Rechargeable, 10000mAh Electric Heated Gloves Power Bank Portable Graphene Handwarmers Pouch with 3 Levels & Double-Sided Heating for Hunting Camping Golf Xmas Gifts for Women Men Kids

2Pack Rechargeable Hand Warmer, 8000mAh Electric Hand Warmer Power Bank, Portable USB-C Hand Warmer for Pocket, Reusable Hand Warmer Up to 8 hrs Each, Warm Gift for Men Women, for Hunting, Camping

GTOCE Portable Charger,40000mAh Power Bank with 22.5W Fast Charging LED Digital Display Battery Pack with 6 Outputs 2 Inputs, Type C Powerbank Portable Charger for iPhone 16 pro Samsung AirPods,Black

Monster Sleep Ear200, Wireless in-Ear Headphones, Bluetooth 6.0 Sleep Headphones, with ANC Active Noise Cancellation Designed for Side Sleepers, 30 Hours of bass Stereo Sound.

Fvyao Sleep Earbuds, Mini Wireless Earbuds in Ear, Sleep Headphones Design for Side Sleeper, 24H Bass Stereo, Bluetooth 5.4, with ENC Noise Cancelling, IPX6 Waterproof Ear Buds for Android iOS

Monster Sleep Ear100 Ear Buds, Sleep Earbuds with Stereo Sound, Design for Side Sleeper, 32H Playtime, Bluetooth 6.0, ENC Noise Cancelling, IPX6 Waterproof Mini Headphones, White

Monster Sleep Ear100 Ear Buds, Sleep Earbuds with Stereo Sound, Design for Side Sleeper, 32H Playtime, Bluetooth 6.0, ENC Noise Cancelling, IPX6 Waterproof Mini Headphones, Black

Hydroponics Growing System Indoor Garden - Herb Garden with Grow Light, 15 Pods Stainless Steel Indoor Garden Kit, Auto Timer, Gardening Gift for All Ages

Umbra Triflora Hanging Planter for Window, Indoor Herb Garden, Set of 5, White/Black

Large Hydroponics Growing System 14 Pods, Indoor Herb Garden with LED Grow Light, 5L Water Tank, Hydroponic Grow Kit with 3 Auto-Timers, Rotatable Light Panel and Child Lock for Home School Gardening

Hanging Planter Hanging Plant Holder, 6 Inch 4 Indoor Plant Pots, Wall/Window Plant Hanger Indoor Herb Garden

slopehill Multi Hair Stylers & Hair Straightener - 2 in 1 Wet to Dry Air Straightener and Hair Dryer Combo with High Speed Air + Rapid Heat-Up + Customizable Temperature(Pink)

Hi.FANCY Portable Laptop Stand with Dual Cooling Fans for 14-17inch Laptops, Grey, 23.5 x 25.9 x 0.95cm

Laptop Stand for Desk, Adjustable Laptop Riser ABS+Silicone Foldable Portable Laptop Holder, Ventilated Cooling Notebook Stand for 10-15.6β Laptops,Tablet-Black

JETech 5 in 1 Case for Samsung Galaxy S25 Ultra 5G with 2-Pack Each Tempered Glass Screen Protector and Camera Lens Protector, Non-Yellowing Shockproof Bumper Phone Cover (Clear)

TAURI for iPhone 17 Pro Max Case 6.9" with 1-Pack Screen Protector, Camera Lens Full Protection, Military-Grade Protection, Shockproof Transparent Back Bumper Phone Cover - Clear Global Recycled Standard

TAURI for iPhone 17 Pro Case 6.3" with 1-Pack Screen Protector, Camera Lens Full Protection, Military-Grade Protection, Shockproof Transparent Back Bumper Phone Cover - Clear Global Recycled Standard

JOINPAYA 1Set Rechargeable Hand Warmer Hand Heater for Winter Heating Levels Compact

Shakven Rechargeable Hand Warmer | Cute Comfortable Portable Hand Warmers,Ergonomic Adjustable Energy-Efficient Small Heater for Travel, Outdoor, Winter

OCOOPA IP45 Waterproof Hand Warmer Rechargeable, Up to 15hrs Heat,10000mAh Durable Quick Charge Electric Hand Heater, PD Compatible, 3 Levels for Outdoors, Heavy Duty, H01-PD PRO